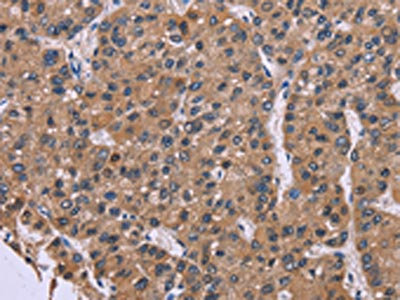

FGFR2 Antibody
-
中文名稱:FGFR2兔多克隆抗體
-
貨號:CSB-PA151107
-
規(guī)格:¥1100
-
圖片:
-
The image on the left is immunohistochemistry of paraffin-embedded Human thyroid cancer tissue using CSB-PA151107(FGFR2 Antibody) at dilution 1/20, on the right is treated with synthetic peptide. (Original magnification: ×200)
-
The image on the left is immunohistochemistry of paraffin-embedded Human liver cancer tissue using CSB-PA151107(FGFR2 Antibody) at dilution 1/20, on the right is treated with synthetic peptide. (Original magnification: ×200)
-
-
其他:
產(chǎn)品詳情
-
Uniprot No.:
-
基因名:
-
別名:FGFR2; BEK; KGFR; KSAM; Fibroblast growth factor receptor 2; FGFR-2; K-sam; Keratinocyte growth factor receptor; CD antigen CD332
-
宿主:Rabbit
-
反應(yīng)種屬:Human,Mouse
-
免疫原:Synthetic peptide of Human FGFR2
-
免疫原種屬:Homo sapiens (Human)
-
標(biāo)記方式:Non-conjugated
-
抗體亞型:IgG
-
純化方式:Antigen affinity purification
-
濃度:It differs from different batches. Please contact us to confirm it.
-
保存緩沖液:-20°C, pH7.4 PBS, 0.05% NaN3, 40% Glycerol
-
產(chǎn)品提供形式:Liquid
-
應(yīng)用范圍:ELISA,IHC
-
推薦稀釋比:
Application Recommended Dilution ELISA 1:2000-1:5000 IHC 1:50-1:200 -
Protocols:
-
儲存條件:Upon receipt, store at -20°C or -80°C. Avoid repeated freeze.
-
貨期:Basically, we can dispatch the products out in 1-3 working days after receiving your orders. Delivery time maybe differs from different purchasing way or location, please kindly consult your local distributors for specific delivery time.
-
用途:For Research Use Only. Not for use in diagnostic or therapeutic procedures.
相關(guān)產(chǎn)品
靶點詳情
-
功能:Tyrosine-protein kinase that acts as cell-surface receptor for fibroblast growth factors and plays an essential role in the regulation of cell proliferation, differentiation, migration and apoptosis, and in the regulation of embryonic development. Required for normal embryonic patterning, trophoblast function, limb bud development, lung morphogenesis, osteogenesis and skin development. Plays an essential role in the regulation of osteoblast differentiation, proliferation and apoptosis, and is required for normal skeleton development. Promotes cell proliferation in keratinocytes and immature osteoblasts, but promotes apoptosis in differentiated osteoblasts. Phosphorylates PLCG1, FRS2 and PAK4. Ligand binding leads to the activation of several signaling cascades. Activation of PLCG1 leads to the production of the cellular signaling molecules diacylglycerol and inositol 1,4,5-trisphosphate. Phosphorylation of FRS2 triggers recruitment of GRB2, GAB1, PIK3R1 and SOS1, and mediates activation of RAS, MAPK1/ERK2, MAPK3/ERK1 and the MAP kinase signaling pathway, as well as of the AKT1 signaling pathway. FGFR2 signaling is down-regulated by ubiquitination, internalization and degradation. Mutations that lead to constitutive kinase activation or impair normal FGFR2 maturation, internalization and degradation lead to aberrant signaling. Over-expressed FGFR2 promotes activation of STAT1.
-
基因功能參考文獻(xiàn):
- The results showed no association between two SNPs, rs1219648 and rs2981582, and breast cancer risk, although in a stratified analysis rs2981582 strongly associated with premenopausal and ER-positive breast cancer in Chinese patients. PMID: 30480917
- The consequent appearance of the mesenchymal FGFR2c variant in the epithelial context would drive early steps of carcinogenesis. PMID: 29068468
- FGFR2 was shown to be markedly overexpressed in gastric cancer tissues and correlated with a high risk of lymph node metastasis and late clinical stage. FGFR2 was negatively associated with TSP4 and FGFR2 activation could downregulate TSP4 expression, which played an important role in the proliferation, invasion and migration of gastric cancer cells. PMID: 30355943
- In male breast cancer, smoking habits had a significant effect on overall survival at 10 years. In the same multivariate analysis, we found a significantly higher overall survival in cases with FGFR2 rs2981582 variant in the dominant transmission model A sensitivity analysis with left truncation showed similar results. PMID: 29709729
- Results showed that HER2 and FGFR2 are regulated by DDX6 at the post-transcriptional step in gastric cancer. PMID: 29987267
- High FGFR2 expression is associated with epithelial ovarian cancer cell proliferation and invasion. PMID: 29970688
- There is a wide spectrum of mutations in FGFR2 shown to be causative for Pfeiffer syndrome. Here we report the first Chinese three-generation family with FGFR2 mutation c.514_515delGCinsTT (p.Ala172Phe). PMID: 29782338
- It was concluded that miR494 inhibited the cancer initiating cells phenotype and reversed resistance to lapatinib by inhibiting FGFR2 in HER2positive gastric cancer. PMID: 29786108
- Patients with very strong FGFR2 mRNA expression showed more homogeneous FGFR2 mRNA expression compared to patients with lower FGFGR2 mRNA expression PMID: 28852882
- provide a comprehensive update on FGFR2-related syndromic craniosynostosis PMID: 29230096
- The mutations were not present in any of the unaffected family members or unrelated control subjects. These findings expand the mutation spectrum of FGFR2, and are valuable for genetic counseling in addition to prenatal diagnosis in patients with Crouzon syndrome. PMID: 28901406
- Fibroblast growth factor receptor 2 (FGFR2) splice site variants were identified in eight patients with Crouzon or Pfeiffer syndrome. PMID: 26841243
- Data suggest that the SOX9 transcription factor (SOX9)-fibroblast growth factor receptor 2 (FGFR2b) feed-forward loop has a lineage dependency role in pancreatic ductal adenocarcinoma (PDAC). PMID: 28796141
- this study reports for the first time the p.W290G mutation in patients with PS. Based on clinical features, genetic, and computational analysis and genotype-phenotype association studies PMID: 28815901
- Studies indicate that switching from fibroblast growth factor receptor 2 (FDFR-2) IIIb to IIIc variants correlates with the aggressiveness of the cancers via epithelial-mesenchymal transition [Review]. PMID: 28930565
- These results unveil the complexity of ER regulation by FGFR2-mediated signaling likely to be associated with BCa resistance to endocrine therapy. PMID: 28869838
- Study report that 5-10% of epidermal nevi harbor embryonic postzygotic FGFR2 activating mutations. PMID: 27103312
- this study identified an FGFR2 in two Chinese patients with syndromic craniosynostosis. The finding expands the reported mutation spectrum of FGFR2, and is of great value for genetic counseling and prenatal diagnosis in families with syndromic craniosynostosis. PMID: 28849010
- Through a stratification analysis, 5q11.2/MAP3K1 (rs16886034, rs16886364, rs16886397, rs1017226, rs16886448) and 7q32.3/LINC-PINT (rs4593472) were associated with Luminal A, and 10q26.1/FGFR2 (rs35054928) was associated with Luminal B. PMID: 28408616
- SNORD126 activates the PI3K-AKT pathway by upregulation of FGFR2. PMID: 27913571
- This study reveals a direct binding event and characterizes the role of TRPA1 ankyrin repeats in regulating FGFR2-driven oncogenic process; a mechanism that is hindered by miRNA-142-3p PMID: 29038531
- Although FGFR2 amplification is associated with poorer OS, it does not appear to be an independent prognostic predictor in patients with advanced gastric cancer treated with palliative fluoropyrimidine and platinum chemotherapy. PMID: 27802183
- This meta-analysis of case-control studies provides strong evidence that FGFR2 (rs2981582, rs2420946 and rs2981578) polymorphisms were significantly associated with the BC risk. PMID: 27966449
- we further refine the influence of variants in the FGFR2 locus with respect to molecular characteristics of breast tumors, in that they are more strongly associated with estrogen receptor status among cancers without amplification of the HER2 gene. PMID: 27764800
- Suggest FGFR2 as a novel acute myeloid leukemia susceptibility gene with a haplotype TT (rs7090018 and rs2912759) showing significant association with AML. PMID: 27903959
- Result demonstrated that FGFR2 high-expression was significantly associated with unfavorable prognosis of gastric adenocarcinoma and that SPRY2 could inhibit FGFR2-induced ERK phosphorylation and suppress FGFR2-elicited gastric cancer cell proliferation and invasion. PMID: 28002800
- By means of structural (X-ray and NMR) and functional characterization of pathogenic gain-of-function mutations affecting the FGF receptor (FGFR) tyrosine kinase domain, the authors elucidated a long-distance allosteric network composed of four interconnected sites termed the 'molecular brake', 'DFG latch', 'A-loop plug', and 'alphaC tether'. The first three sites repress the kinase from adopting an active conformation... PMID: 28166054
- Besides, we found miR-628-5p targeted at and down-regulated the expression of fibroblast growth factor receptor 2 (FGFR2). FGFR2 expressed higher in ovarian cancer tissues and was correlated with worse prognosis. Our findings indicated that miR-628-5pplays an important role in ovarian cancer stem cell driven tumorigenesis. PMID: 29229394
- Mandibular growth in children with FGFR2 mutations is not normal with impairments found in forward sagittal growth and skull base widening PMID: 28468153
- Inhibiting Fgf-R partly reversed alphavbeta3 integrin activity in Mll-Ell+ progenitor cells. PMID: 27340869
- In gastric cancer, FGFR2 protein overexpression predicts gene amplification and poor survival. PMID: 27230412
- Her2, cMet and FGFR2 statuses were profiled in gastric cancer (GC) patients and the -derived tumor xenograft(PDX) models. PMID: 28292264
- We demonstrate that the bent bone dysplasia syndrome mutations in FGFR2 p.M391R and p.Y381D augment the ability of FGFR2 to epigenetically activate rDNA. Mutations p.M391R and p.Y381D activate the p53 nucleolar stress response pathway and alter FGFR2-mediated activation of ribosome biogenesis. PMID: 28595297
- Polyclonal secondary FGFR2 mutations represent an important clinical resistance mechanism to protein kinase inhibitors in patients with FGFR2 fusion-positive cholangiocarcinoma. PMID: 28034880
- CD44 and FGFR2 maintain stemness in gastric cancer by differentially regulating c-Myc transcription. PMID: 27107424
- a novel identical postzygotic activating FGFR2 mutation in two unrelated fetuses with papillomatous pedunculated sebaceous naevus. PMID: 27095246
- Findings suggest fibroblast growth factor receptor 2 (FGFR2) as a therapeutic target for esophagogastric junction (EGJ) adenocarcinoma. PMID: 26933914
- Description of these patients expands the prenatal and postnatal findings of Bent Bone Dysplasia-FGFR2 type and adds to the phenotypic spectrum among all FGFR2 disorders. PMID: 27240702
- Our results imply that the same FGFR2 mutations result in diverse phenotypes, and that genetic studies are recommended not only for obviously affected individuals but also for family members with apparently normal phenotype or non-specific subtle abnormal phenotype. PMID: 27683237
- Liensinine inhibits FGFR2 activity. PMID: 28132898
- FGFR2-ACSL5 fusion is associated with resistance to LY2874455 in FGFR2-amplified gastric cancer . PMID: 28122360
- FGFR2 mutation is associated with endometrial carcinoma progression and abdominopelvic metastasis. PMID: 27348297
- FGFR inhibitors, particularly BGJ398, are therapeutic options for cholangiocarcinoma patients harboring FGFR2-CCDC6 fusions. PMID: 27216979
- High FGFR2 expression is associated with Gastric Cancers. PMID: 27197184
- Two novel FGFR 2 gene missense mutations in Chinese patients with Crouzon syndrome were identified. PMID: 27430617
- Incidence of progression (progressed, recurred or died from disease) of endometrioid endometrial cancer was significantly more prevalent (32/125, 26%) among patients with FGFR2 mutation versus wild type (120/848, 14%; p<0.001, Chi-square test). PMID: 28314589
- We show that this stabilizes the tyrosine and primes it for the catalytic phosphotransfer, and it may lower the activation barrier of the phosphotransfer reaction. Our work demonstrates the value of including dynamic information gleaned from computer simulation in deciphering RTK regulatory function. PMID: 28151998
- We show that the decrease in PI(4,5)P2 level under non-stimulated conditions inhibits PTEN activity leading to the aberrant activation of the oncoprotein Akt. As well as defining a novel mechanism of Akt phosphorylation with important therapeutic consequences, we also demonstrate that differential expression levels of FGFR2, Plc11 and Grb2 correlate with patient survival PMID: 26212011
- High FGFR2 expression was significantly associated with the depth of invasion, lymph-node metastasis, pathological stage, and distant metastasis or recurrent disease in gastric cancer. PMID: 28056982
- fibroblast growth factor receptor 2 overexpression is correlated with decreased survival in most solid tumors, suggesting that the expression status of fibroblast growth factor receptor 2 is a valuable prognostic biomarker and a novel therapeutic target in human solid tumors. PMID: 28618942
顯示更多
收起更多
-
相關(guān)疾病:Crouzon syndrome (CS); Jackson-Weiss syndrome (JWS); Apert syndrome (APRS); Pfeiffer syndrome (PS); Beare-Stevenson cutis gyrata syndrome (BSTVS); Familial scaphocephaly syndrome (FSPC); Lacrimo-auriculo-dento-digital syndrome (LADDS); Antley-Bixler syndrome, without genital anomalies or disordered steroidogenesis (ABS2); Bent bone dysplasia syndrome (BBDS); Saethre-Chotzen syndrome (SCS)
-
亞細(xì)胞定位:Cell membrane; Single-pass type I membrane protein. Golgi apparatus. Cytoplasmic vesicle. Note=Detected on osteoblast plasma membrane lipid rafts. After ligand binding, the activated receptor is rapidly internalized and degraded.; [Isoform 1]: Cell membrane; Single-pass type I membrane protein. Note=After ligand binding, the activated receptor is rapidly internalized and degraded.; [Isoform 3]: Cell membrane; Single-pass type I membrane protein. Note=After ligand binding, the activated receptor is rapidly internalized and degraded.; [Isoform 8]: Secreted.; [Isoform 13]: Secreted.
-
蛋白家族:Protein kinase superfamily, Tyr protein kinase family, Fibroblast growth factor receptor subfamily
-
數(shù)據(jù)庫鏈接:
Most popular with customers
-
-
YWHAB Recombinant Monoclonal Antibody
Applications: ELISA, WB, IHC, IF, FC
Species Reactivity: Human, Mouse, Rat
-
-
-
-
-
-